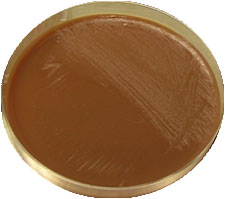

Quand les signes cliniques de l'élevage et les lésions observées sur les porcelets font suspecter une infection par Haemophilus parasuis (voir le chapitre " Diagnostic clinique et pathologique "), on doit confirmer ce diagnostic au laboratoire.

![]() |
|
Fig. 1 Coloration de Gram d'Haemophilus parasuis. On observe des bacilles gram negatifs courts et d'autres plus grands (pléomorphisme).
|
Depuis que Glässer a remarqué l'association entre un bacille et les lésions de polysérosite chez des porcelets, 32 années se sont écoulées jusqu'à ce qu'Hjärre et Wramby aient obtenu son isolement au laboratoire en 1943. Depuis ce temps-là, l'isolement d'Haemophilus parasuis à partir de lésions caractéristiques de la maladie de Glässer est la technique concluante ou "gold standard " pour le diagnostic de cette maladie. Cependant, H. parasuis est une bactérie labile, avec des besoins complexes pour se développer en laboratoire et dont l'isolement en culture pure peut être difficile. Pour augmenter les chances de succès de l'isolement de cette bactérie, il est essentiel de disposer d'échantillons appropriés, prélevés en évitant une contamination et transportés convenablement.
Les échantillons doivent être prélevés sur des animaux présentant la forme aiguë de la maladie, principalement avec signes de détresse respiratoire ou d'arthrite, mais aussi sur ceux présentant des signes nerveux. Si c'est possible, on choisira les animaux qui n'ont pas été traités aux antibiotiques.
Les animaux atteints de forme chronique ne sont pas représentatifs, puisqu'on ne peut pas isoler la bactérie de leurs lésions chroniques (polysérosite fibreuse). Les prélèvements doivent être faits à partir de lésions systémiques (péricardite, arthrite, péritonite, …) à l'aide d'écouvillons ou en recueillant des échantillons de liquides accumulés dans les différentes cavités. Chez des animaux aux symptômes nerveux, on peut aussi prélever un échantillon de liquide céphalo-rachidien. Les échantillons de poumon ne sont pas appropriés pour le diagnostic de la maladie de Glässer et doivent être utilisés quand les animaux présentent uniquement de la pneumonie, car H. parasuis est un colonisateur du tractus respiratoire supérieur des porcelets et la présence de la bactérie dans le poumon peut être due à une invasion post-mortem depuis le nez. On isolerait ainsi une souche d'H. parasuis qui ne serait pas réellement impliquée dans la maladie. Pour cette même raison on ne peut pas utiliser de prélèvements faits sur des nez ou des amygdales pour le diagnostic. Pour augmenter les possibilités de survie de la bactérie, les échantillons doivent être transportés au laboratoire le plus tôt possible (moins de 2 jours) et en milieu de transport réfrigéré.
![]() |
|
Fig. 2 Croissance d'Haemophilus parasuis en en culture pure sur une gélose au chocolat.
|
H. parasuis est un bacille gram-négatif de la famille des Pasteurellaceae et a besoin de NAD pour se développer. Ainsi, au laboratoire, il se développe sur de la gélose au chocolat (fig. 2) ou sur de la gélose au sang avec une strie de Staphylococcus qui lui fournit le NAD. H. parasuis grandit lentement et a besoin de 1 à 3 jours pour produire de petites colonies. L'identification d'H. parasuis doit prendre en compte la différenciation de bactéries similaires comme Actinobacillus minor, Actinobacillus indolicus et Actinobacillus porcinus. Cette différenciation est importante parce que ces Actinobacillus peuvent aussi être isolés du tractus respiratoire des porcs et, bien qu'on les considère peu nombreux ou non pathogènes, on les a isolés en culture pure de poumons pneumoniques ou même de lésions systémiques dans le cas d'A. porcinus.
La différenciation peut être réalisée grâce à des tests biochimiques, particulièrement par la production d'indole et la mesure des activités uréase et catalase.
Tableau 1. Différenciation d'Haemophilus parasuis et Actinobacillus minor, A. indolicus et A. porcinus par des tests biochimiques
|
H. parasuis
|
A. minor
|
A. indolicus
|
A. porcinus
|
|
| Catalase |
+
|
-
|
+
|
-
|
| Indole |
-
|
-
|
+
|
-
|
| Uréase |
-
|
+
|
-
|
-
|
![]() |
|
Fig. 3 PCR spécifique pour la détection d'Haemophilus parasuis.
1: marqueur de poids moléculaire 2: échantillon négatif ; pas de détection d'H. parasuis. 3: échantillon positif, lésion produite par H. parasuis. |
L'introduction de la PCR dans le diagnostic des maladies infectieuses a présenté un avantage dans le diagnostic des micro-organismes à culture difficile ou à croissance très lente. Dans le cas d'H. parasuis la PCR la plus utilisée est celle publiée par Oliveira et al. en 2001.
Cette technique peut remplacer l'identification biochimique des isolements bactériens ou être utilisée directement sur des échantillons cliniques. Dans ce dernier cas, cette PCR a une sensibilité de 102 CFU/ml.
Comme pour l'isolement, les échantillons nasaux ou d'amygdales ne sont pas appropriés au diagnostic. Dans les cas pour lesquels on ne peut pas réaliser l'isolement, par exemple si on a un nombre excessif d'échantillons, cette PCR spécifique peut aider au diagnostic (fig. 3). Cependant, le fait de disposer de l'isolement bactérien permet de réaliser des tests additionnels, comme la sensibilité aux antimicrobiens ou le typage qui aident au contrôle de la maladie.
| Observations Qu'il s'agisse d'isolement bactérien ou de PCR, le résultat de l'analyse dépend en premier lieu du choix des échantillons : - sur des animaux en phase aiguë, non traités - sur des lésions systémiques. Pour limiter encore le risque de faux négatifs (possible même sur animaux infectés expérimentalement, selon le type d'échantillon (Palzer et al., 2010) il conviendrait donc de multiplier les prélèvements (écouvillons des membranes séreuses et LCR) et, si possible, d'associer les deux méthodes. |
Virginia Aragón. CRESA. Espagne